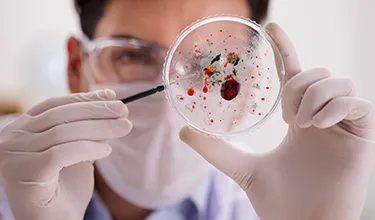

The ongoing battle against dengue

Successful past campaigns
Campaigns to remove dengue mosquitoes were very successful in the 1950s and 1960s. In fact, by the early 70s Aedes aegypti mosquitoes had been eradicated in 21 countries.1 Recently though, dengue cases have been on the rise again globally.2
Hitting back: Global collaboration milestones
Recently, many global organizations, governments, and communities have joined forces to tackle dengue:

Assembling an expert team
The International Dengue Task Force was created as a combination of experienced teams, each with their own areas of expertise:5
Epidemiological Surveillance: Knowledge of the principles and recent advances in epidemiology, surveillance, and biostatistics
Laboratory Procedures: Experience in different diagnostic techniques for dengue
Case Management: Early detection of cases, management of severe dengue, and education of health workers
Mass Communications: New communication strategies to help behaviour and the health authorities reach the community
Vector-Control Activities: Mosquito control and environmental management activities
Modern problems and modern solutions
Other, more localized and novel techniques have also been attempted, such as:6
Mapping dengue hotspots: to help locate areas with high dengue cases and more targeted preventive measures
Use of effective surveillance systems: to provide timely responses to dengue outbreaks
Destruction of mosquito breeding sites: such as water containers
Community-based control programs: educating communities about mosquito breeding sites and control
Biological control methods: like introducing genetically modified bacteria or using sterile male mosquitoes to help suppress the dengue vector population
Using fish and plant-based insecticides: to provide eco-friendly and cost-effective options for controlling mosquitoes
Chemical control methods: such as insecticides and insect growth regulators, to prevent the growth and development of mosquitoes
Use of pheromones: used to attract and kill mosquitoes
The struggle with dengue continues
Unfortunately, traditional strategies to combat dengue have not been satisfactory and it remains a major global public health threat – global cases have surged 10-fold from 2000-2019.6-8 Since the founding of The International Dengue Task Force in 2003, global dengue cases reported have reached new heights, with a new record set in 2019.1,2 According to the WHO, more and more countries are reporting their first outbreaks and, explosive outbreaks are occurring across Europe.2
As it stands, about half of the world's population is now at risk of dengue, with an estimated 100–400 million infections occurring each year.2
If you are worried about dengue or have any other healthcare-related questions, please contact your doctor or other healthcare professional promptly.
References
The Pan American Health Organization. Integrated management strategy for dengue prevention and control. Available at: https://www.paho.org/en/topics/dengue/integrated-management-strategy-dengue-prevention-and-control. Accessed November 2023.
World Health Organization. Dengue and Severe Dengue. Available at: https://www.who.int/news-room/fact-sheets/detail/dengue-and-severe-dengue. Accessed January 2024.
Devine GJ, et al. Trends Parasitol. 2019;35(4):267-270.
World Health Organization. Neglected tropical diseases: Global vector control response 2017-2030. Available at: https://www.who.int/news-room/questions-and-answers/item/neglected-tropical-diseases-global-vector-control-response-2017-2030. Accessed January 2024.
The Pan American Health Organization. The International Dengue Task Force: Dedicated to the Fight against Dengue. Available at: https://www.paho.org/en/topics/dengue/international-dengue-task-force-dedicated-fight-against-dengue. Accessed November 2023.
Rather IA, et al. Front. Cell. Infect. Microbiol. 2017;7:336.
Rodriguez-Manzano J, et al. Curr Infect Dis Rep. 2018;20(8):25.
World Health Organization. Dengue - Global situation. Available at: https://www.who.int/emergencies/disease-outbreak-news/item/2023-DON498. Accessed January 2024.
World Health Organization. Global Strategy For Dengue Prevention And Control. Available at: https://apps.who.int/iris/bitstream/handle/10665/75303/9789241504034_eng.pdf. Accessed November 2023.